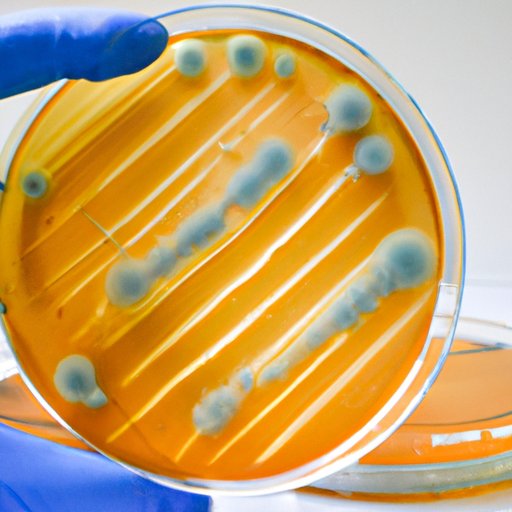

I. Introduction
Microbiology plays a critical role in many industries such as food production, healthcare, and environmental control. To isolate and identify bacteria correctly, microbiologists have developed various tools and techniques, including selective media. Mannitol salt agar is one of the most commonly used selective media in the laboratory. This article explores mannitol salt agar selectivity for Staphylococcus species.
II. Mannitol Salt Agar: The Selective Tool for Staphylococcus Aureus Detection
Mannitol salt agar (MSA) is a commonly used, selective and differential media used for the growth and identification of Staphylococcus species. The media’s name describes its important components, namely mannitol and salt.
The selective attribute of MSA makes it an indispensable tool for microbiologists in the isolation and enumeration of bacteria. Selective media contain compounds that provide selectivity by allowing the growth of some species while limiting the growth of others.
The genus Staphylococcus comprises spherical, non-motile, and gram-positive bacteria that are members of the family Staphylococcaceae. Staphylococcus aureus, the most common member of this genus, is a well-known human pathogen that can cause various infections. Mannitol salt agar is a selective tool that can detect Staphylococcus species such as S. aureus.
III. How Mannitol Salt Agar Selects for Staphylococcus Species
Mannitol salt agar contains several essential ingredients, including:
- Peptone, which provides nitrogen, amino acids, and other nutrients
- Mannitol, a sugar alcohol that serves as the fermentable substance
- Sodium chloride, which makes the media selective
- Phenol red, an indicator that detects acid production by fermenting bacteria
The high salt concentration inhibits the growth of most bacteria except Staphylococcus spp., which tolerate such high salinities. The mannitol sugar in the media ferments to produce acid, and subsequent acid production changes the media’s pH to a yellow color.
Staphylococcus spp. can ferment mannitol and change the pH of the media from red to yellow due to the release of acidic substances such as lactic and acetic acids. The yellow color indicates a positive test, which is typical of Staphylococcus aureus.
IV. A Comprehensive Guide to Mannitol Salt Agar and Its Selectivity for Staphylococcus
If you are a microbiologist, you will want to select a selective media such as Mannitol Salt Agar to provide a more stable and robust environment to facilitate the growth of your desired organism. Here is a comprehensive guide to making and using MSA:
1. Prepare media ingredients according to the manufacturer’s instructions.
2. Heat the mixture in a water bath or autoclave.
3. After autoclaving, allow it to cool down to approximately 45°C.
4. Dispense the media into Petri dishes.
5. Allow the media to cool to room temperature and store accordingly until ready for use.
Mannitol Salt Agar is a selective tool for identifying Staphylococcus species. Microbiologists need to use good laboratory practices when using this medium to achieve accurate results. Typical colony morphology to look for when using MSA includes:
- Colonies appearing yellow with yellow zones around them indicate S. aureus.
- Colonies appearing yellow with no zones are indicative of other coagulase-positive Staphylococci species.
- Colonies appearing red or pink are non-Staphylococcus species.
Mannitol Salt Agar’s selectivity provides a reliable means of detecting Staphylococcus species. However, microbiologists must be aware of MSA’s limitations. Careful interpretation of test results is essential, and further testing is necessary to confirm the identification of Staphylococcus spp.
V. Mannitol Salt Agar: The Gold Standard for Identifying Staphylococcus Genus
Mannitol salt agar remains the most commonly used and preferred method for the examination of Staphylococcus spp. It is an excellent tool for the primary isolation and differentiation of Staphylococcus aureus from other Staphylococci that colonize the human body.
Some other media used for the identification of Staphylococci include CHROMagar, Coagulase Test, and Baird-Parker Agar. However, Mannitol Salt Agar remains the gold standard for selecting and identifying Staphylococcus spp.
VI. Why Mannitol Salt Agar Is an Effective Means of Selecting for Staphylococcus Bacteria
Mannitol salt agar has several advantages in Staphylococcus detection. The media’s high salt content inhibits the growth of all bacteria except Staphylococcus spp. The mannitol fermented by Staphylococcus spp. produces acidic substances such as lactic and acetic acids, which change the media’s pH resulting in a distinct yellow color. Mannitol salt agar provides accurate, reliable, and replicable results, making it an effective tool for the isolation and identification of Staphylococci.

VII. Staphylococcus Detection Made Simple: The Role of Mannitol Salt Agar
Here are some tips for successful Staphylococcus detection with Mannitol Salt Agar:
- Use aseptic techniques to avoid contamination.
- Observe the triple-zone type of hemolysis using a blood agar plate while setting up the culture.
- The incubation of the Petri dishes must be carried out at 30-35 degrees Celsius in a location that is not too moist.
- Use selective media like mannitol salt agar to facilitate the growth and isolation of Staphylococcus spp.
- Ensure that the incubation is minimal, usually 24-48 hours.
By following these tips, microbiologists can increase the likelihood of accurately detecting Staphylococcus spp. using mannitol salt agar.
VIII. Navigating the Selectivity of Mannitol Salt Agar and Its Link to Staphylococcus Identification
The selectivity of Mannitol salt agar is critical in facilitating Staphylococcus spp. detection. The high salt concentration in the media prevents the growth of most bacteria other than Staphylococcus spp. The mannitol sugar in the media ferments to produce acid, which can change the media’s pH to a yellow color. The acidic pH resulting from the fermentation of mannitol by Staphylococcus spp. provides an excellent means for the identification of Staphylococci.
IX. Conclusion
Mannitol salt agar is a critical selective and differential media for the identification of Staphylococci, especially S. aureus. Its high salt content and molasses sugar content inhibit the growth of almost all bacteria and allow for the selective isolation of Staphylococcus spp. The selectivity provides accurate results that are reliable, repeatable, and essential in various industries.
Mannitol salt agar is a relatively simple medium to make and use; however, it would be best to adhere to good laboratory practice during the preparation, incubation, and interpretation stages of your tests.
By following the tips and guidelines outlined in this article, microbiologists can rely on Mannitol salt agar to identify Staphylococcus spp. with high accuracy and reliability.